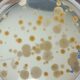

El INTA Famaillá continúa aportando conocimientos y herramientas para combatir la chicharrita del maíz (Dalbulus maidis), un insecto vector del complejo de enfermedades del achaparramiento. Con...

Investigadores del INTA Famaillá destacan la importancia de la microbiología del suelo para mejorar la productividad y sostenibilidad del cultivo de caña de azúcar en Tucumán....



El cultivo de nuez pecán ha crecido significativamente en el NOA y otras regiones del país, impulsando nuevas investigaciones para mejorar su producción. En este contexto,...



El INTA Famaillá advirtió sobre un incremento del 18% en las poblaciones de chicharrita (Dalbulus maidis) en la región del Noroeste Argentino (NOA), un fenómeno que...



La campaña de maíz en el norte de Argentina enfrenta desafíos significativos debido a la reducción en las proyecciones de cosecha y la persistente amenaza de...